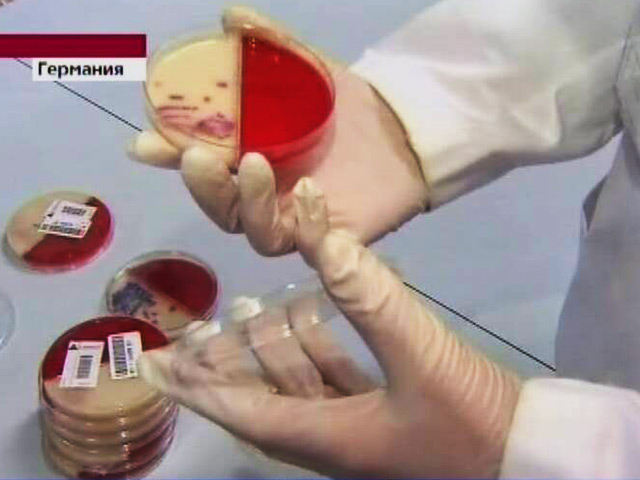

Смертельно опасная кишечная инфекция могла попасть в Чехию, Австрию и Венгрию
Власти Чехии задержали партию потенциально зараженных кишечной палочкой огурцов из Испании и предупредили, что потенциально опасная продукция попала также в Австрию и Венгрию, сообщает агентство AP со ссылкой на администрацию по надзору за продуктами и агрокультурой Чехии.
Власти ФРГ заявили ранее, что салатные огурцы из Испании оказались носителями кишечной инфекции, из-за которой в стране тяжело заболели более 600 человек, а десять из них умерли, сообщает РИА "Новости".
В воскресенье потенциально опасная продукция была снята с продажи в Чехии. Между тем, чешские инспекторы сообщили, что испанские салатные огурцы из той же партии были поставлены в Австрию, Венгрию и Люксембург. На данный момент из этих стран нет сообщений о заболевших острой кишечной инфекцией.
Эпидемиологи также проверяют поступившую информацию о возможном выявлении кишечной инфекции после употребления огурцов в Швеции и Дании. По предварительным данными, в этих странах около десяти человек почувствовали недомогание, вернувшись из поездки в Германию. Восемь из них были госпитализированы в связи с выявлением кишечной палочки.
Инфекцию вызывает так называемая энтерогеморрагическая бактерия Escherichia coli (кишечная палочка). Согласно данным Всемирной организации здравоохранения (ВОЗ), бактерия E. coli часто присутствует в кишечнике людей и теплокровных животных. Большинство ее штаммов безвредны, но некоторые штаммы, такие как энтерогеморрагическая кишечная палочка (EHEC), могут вызывать тяжелые болезни пищевого происхождения.
По данным ВОЗ, бактерия передается человеку, главным образом, при употреблении в пищу зараженных продуктов, таких как сырые или не прошедшие достаточную тепловую обработку мясные продукты или сырое молоко. Также источником заражения могут быть прошедшие недостаточную тепловую обработку овощи. Специалисты рекомендуют в связи с этим соблюдать правила гигиены при приготовлении пищи и тщательно мыть овощи.
Симптомы вызываемых бактериями EHEC болезней - кровавая диарея, жар, рвота. Большинство пациентов выздоравливает в течение 10 дней, но у незначительного числа пациентов (детей раннего возраста и пожилых людей) болезнь может принять тяжелую форму с угрозой для жизни.